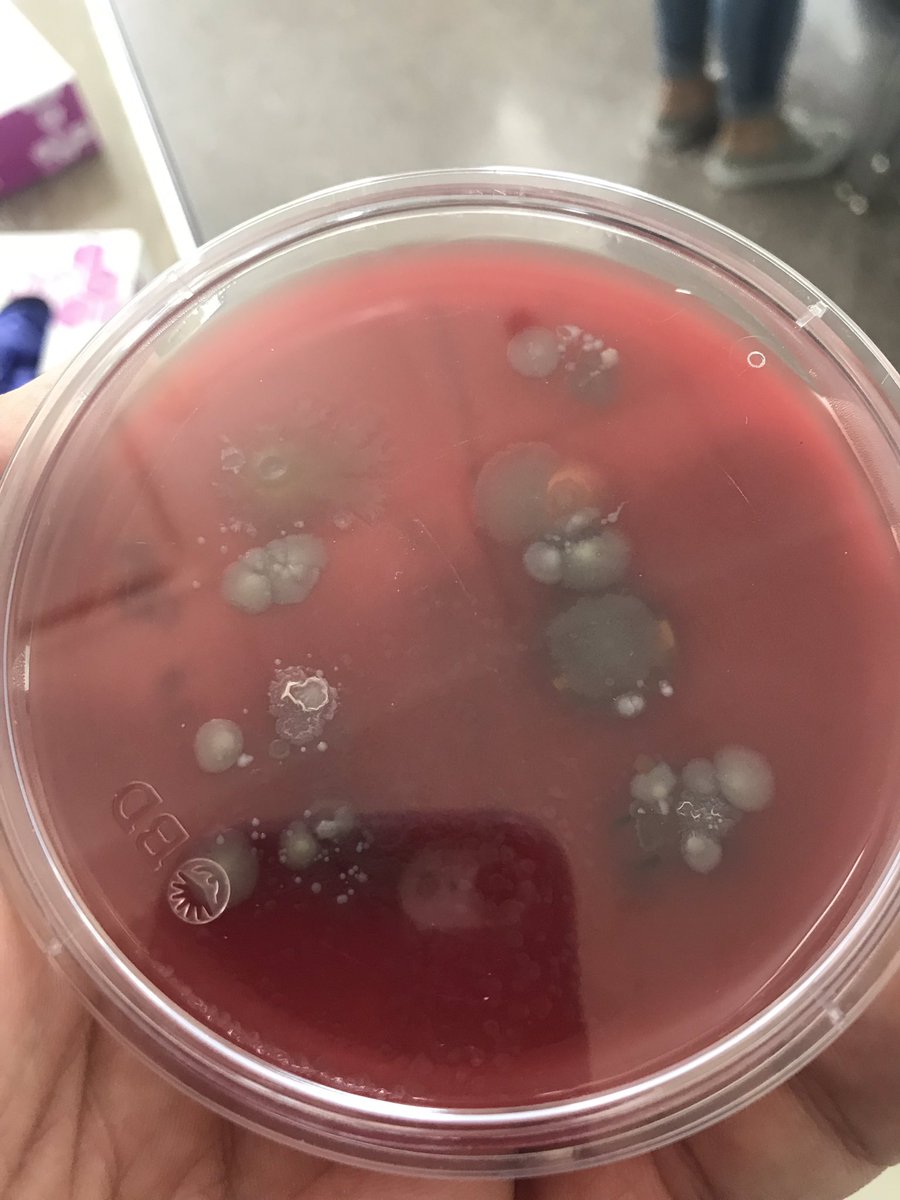
Just another example of the real world quality of CTE.  Health Occupations students testing their blood to determine blood type and inoculating microbiology plates to see what bacteria grows on their finger.
<a href="/sd129/">West Aurora School District 129</a> <a href="/WAAcademics129/">WAAcademics129</a>

WAAcademics129
@waacademics129
ID: 1039945402202636288
12-09-2018 18:34:39
60 Tweet
145 Followers
42 Following

Excited to offer Calculus III for the first time at West Aurora. Mr. Maston and a room full of excellent mathematics students- this is incredible!! UncleBubba West Aurora School District 129 @Jolene_Smith2


Excited for this course! Students getting work experience while still in high school. UncleBubba Brian Veit West Aurora School District 129

Our very first group of students at the Weisner Family Center for Career Development West Aurora School District 129 @jcraig129 #makeadifference129




The More You Know... The density of a substance stay the same regardless of the amount of the substance. Students exploring this concept while engaging in a Chemistry measurement lab with Mr. Feyerer. @KFeyerer78 UncleBubba


The More You Know... SDS stands for Safety Data Sheets- a handbook that contains all of the occupational safety and health information. Learned this from students at the Wiesner Family Career Center as they completed their OSHA 10 training. UncleBubba Brian Veit


The More You Know...A good weightlifting routine includes an "unloading" day every third lift. Helps your body rest and repair. Athletic PE with @Coach_Tokarz3 UncleBubba Todd Gingerich


The More You Know...Types of verbs- Action, Be, State of Being, Weak Helping and Strong Helping. Working collaboratively to write sentences with each type of verb. Terri Shepard UncleBubba


Just another example of the real world quality of CTE. Health Occupations students testing their blood to determine blood type and inoculating microbiology plates to see what bacteria grows on their finger. West Aurora School District 129 WAAcademics129

2020 AP Exam Registration Information is now available. Ask your teacher or counselor for more information. UncleBubba


The More you Know...JROTC cadets work towards 12 hours of community service every year. Great start today in the West High courtyards! UncleBubba


Future Huskies NIU? West Aurora High school students using their day off to go on college visits! Thank you to the WAHS College and Career Center for planning these visits. UncleBubba West Aurora School District 129


Proud to represent Waubonsee CC. Our partnership provides so many great opportunities for our students to earn dual credit and start their road to college completion. Thanks to Bob Cofield, Director of School District Partnerships, for making it happen. Waubonsee Community College

Proud of the 52 students recognized as Illinois State Scholars. See the full list in the link below. UncleBubba West Aurora School District 129 isac.org/students/befor…

Ready for the College and Career Fair 2020. Find your passion. Find your path. UncleBubba West Aurora School District 129 West Aurora Counseling Department


Excited for the class of 2021. Around 200 seniors here for the first day of SAT testing. West Aurora School District 129 UncleBubba


Organelle speed dating in AP Biology. Students dated other organelles and choose their best match. Smooth jazz and ambiance included. UncleBubba


¿Tienes hambre? Spanish 2 and French 2 students are practicing ordering food in the target language. Thank you to the great Food trucks that participated today. Profe Wolek Colleen Aguilar UncleBubba
